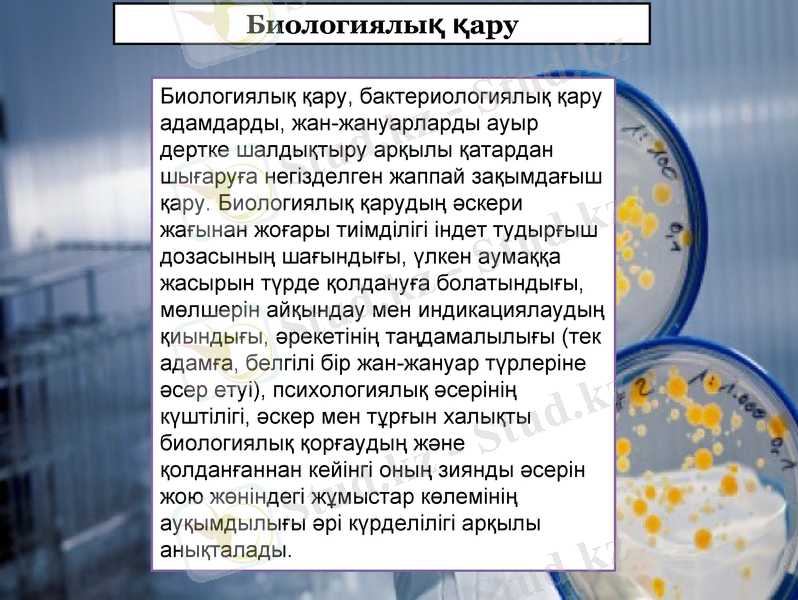
Slide 3

Химиялық және биологиялық қару: түрлері, негізгі қасиеттері, тарихы және қорғану шаралары



Химиялық қару. Биологиялық қару
Тексерген: Калкашев. С. Ғ
Орындаған: «Жас экологтар» тобы
Болат Меңдікөл, Алтаева Айғаным, Нуруллаева Дина, Мысырова Диана
Ыбырай Алтынсарин атындағы педогогикалық институт

Жоспар:
1. Биологиялық қару
2. Биологиялық қарудың түрлері және негізгі қасиеттері
3. Химиялық қару
4. Химиялық қару тарихы
5. Химиялық қарудан қорғану
Биологиялық қару
Биологиялық қару, бактериологиялық қару адамдарды, жан-жануарларды ауыр дертке шалдықтыру арқылы қатардан шығаруға негізделген жаппай зақымдағыш қару. Биологиялық қарудың әскери жағынан жоғары тиімділігі індет тудырғыш дозасының шағындығы, үлкен аумаққа жасырын түрде қолдануға болатындығы, мөлшерін айқындау мен индикациялаудың қиындығы, әрекетінің таңдамалылығы (тек адамға, белгілі бір жан-жануар түрлеріне әсер етуі), психологиялық әсерінің күштілігі, әскер мен тұрғын халықты биологиялық қорғаудың және қолданғаннан кейінгі оның зиянды әсерін жою жөніндегі жұмыстар көлемінің ауқымдылығы әрі күрделілігі арқылы анықталады.

Биологиялық қару - соғыс құралдары ішіндегі адамзат пен қоршаған ортаға ең зиянды қарулардың бірі.

Биологиялық құралдардың түрлері және
негізгі қасиеттері

Бактериялар - формалары мен мөлшерлері әр тұрлі дара шаршылы микроорганизмдер . Олардың мөлшері 0, 5-тен 8-10 мкм-ға дейін болуы мүмкін. Бактериялар дара көлденең бөліктермен тұқым береді, әр 28-30 мин. сайын екі дербес клетка шырарады. Тікелей күн сәулесі, дезинфекщіялау заттары және жоғары температура әсерінен олар тез өліп қалады; төмен температураға төзімді және -25°С дейін мұздауды еркін көтереді. Кейбір бактерия түрлері колайсыз жағдайларда тірі қалу үшін қорғаныш капсуламен жабылуға немесе сырткы орта әсеріне жоғары тұрақтылығы бар ұрыққа айналуға қабіпетті.
Патогендік бактериялар адамдардың (жануарлар) көптеген ауыр жұқпалы ауруларының себебі болып табылады, оның ішінде оба, түйнеме, маңқа және легионеллез және басқалар. Кейбір бактериялар, сыртқы ортада өз дамуына қолайлы жағдайда болса, адамдар (жануарлар) организміне қарсы аса жоғары улылыққа ие болатын және ауыр, жиі өлімге әкеп соқтыратын, зақымдарды шақыратын белсенді тіршілік әрекеті өнімдерін жасайды. Бұл улағыш өнімдердің өміршеңдігі микробты токсиндер атауына ие болды. Шетел мамандардың назары ботулиникалық токсин мен стафилококк энтертоксинге аударылады.
Бактериялар

Саңырауқұлақтар
Саңырауқұлақтар - дара немесе көп клеткалы өсімдіктен пайда болатын микроорганизмдер, олар бактериядан мейлінше күрделі құрылысы және тұқымын көбейту тәсілімен ерекшеленеді. Саңырауқұлақтардың ұрығы кебуге, күн сәулесі мен дезинфекциялау заттар әсеріне өте тұрақты. Цатогендік саңырауқұлақтардан жұққан аурулар адамдар ішкі органдарының зақымдалуымен сипатталады және ауыр я болмаса ұзақ болып келеді. Олардың ішінде мынадай ауыр жұқпалы аурулар бар: кокцидиондомикоз, гистоплазмоз және басқа терең микоздар.

Вирустар - биологиялық агенттердің ең үлкен тобы, биосинтетикалық аппаратты қолданып, олардың тұқым беруге және дамуға қабілетті клеткалы құрылымы жоқ. Клеткадан тыс формадағы вирустардың көлемі 0, 02-ден 0, 4 мкм-ға дейін болуы мүмкін. Олардың көбі сыртқы ортадағы түрлі факторларға: құрғаққа, күн сәулесіне (әсіресе ультракүлгін сәулелерге), сондай-ақ +60°С астам температура мен дезинфекциялау құралдарының (формалин, хлорамин және басқалар) әсеріне тұрақсыз. Патогендік вирустар көптеген ауыр және қауіпті аурулардың себебі болып табылады, атап айтқанда: натуралды шешек, тропикалық геморройлы безгек, аусыл, Рифт алқабының безгегі және басқалар.
Вирустар

Химиялық қару
Химиялық қару - уландырғыш заттар мен құралдарды қолдануға арналған машиналар, приборлар, қару-жарақтар. Химиялық қару жаудың адам күшін жаппай қырып-жоюға арналған. Сондай-ақ белгілі бір жерлерді, қару-жарақты, әскери техниканы, әр түрлі тыл нысандарын уландыру үшін де қолданылуы мүмкін. Химиялық қарудың тиімділігі, көбінесе метеорологиялық жағдайларға, жердің жайына байланысты. Мысалы, ауа райы желді болса, уландырғыш заттардың таралатын аймағы ұлғайып, жел тымық болса, уландырғыш заттар бір жерде ұзақ тұрып қалады.

Химиялық қару тарихы
Химиялық қарулар ұзақ жылдар бойы адам өлтіру құралы ретінде пайдаланылып келеді. Бірақ 20-ғасырда бұл жойқын қару жан шошырлық ауқымда қолданылды. 1914 жылдан бүгінге дейін химиялық қару 1 миллион 500 мың адамды мерт қылып, әйтпесе жаралады. Бірінші дүниежүзілік соғыста хлор, иприт пен фосген;
- Іс жүргізу
- Автоматтандыру, Техника
- Алғашқы әскери дайындық
- Астрономия
- Ауыл шаруашылығы
- Банк ісі
- Бизнесті бағалау
- Биология
- Бухгалтерлік іс
- Валеология
- Ветеринария
- География
- Геология, Геофизика, Геодезия
- Дін
- Ет, сүт, шарап өнімдері
- Жалпы тарих
- Жер кадастрі, Жылжымайтын мүлік
- Журналистика
- Информатика
- Кеден ісі
- Маркетинг
- Математика, Геометрия
- Медицина
- Мемлекеттік басқару
- Менеджмент
- Мұнай, Газ
- Мұрағат ісі
- Мәдениеттану
- ОБЖ (Основы безопасности жизнедеятельности)
- Педагогика
- Полиграфия
- Психология
- Салық
- Саясаттану
- Сақтандыру
- Сертификаттау, стандарттау
- Социология, Демография
- Спорт
- Статистика
- Тілтану, Филология
- Тарихи тұлғалар
- Тау-кен ісі
- Транспорт
- Туризм
- Физика
- Философия
- Халықаралық қатынастар
- Химия
- Экология, Қоршаған ортаны қорғау
- Экономика
- Экономикалық география
- Электротехника
- Қазақстан тарихы
- Қаржы
- Құрылыс
- Құқық, Криминалистика
- Әдебиет
- Өнер, музыка
- Өнеркәсіп, Өндіріс
Қазақ тілінде жазылған рефераттар, курстық жұмыстар, дипломдық жұмыстар бойынша біздің қор #1 болып табылады.



Ақпарат
Қосымша
Email: info@stud.kz